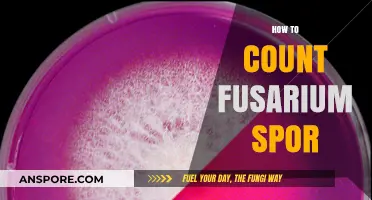
Mastering Fusarium Spore Counting: Techniques and Tools for Accurate Results

Conquering the galaxy in *Spore* is an ambitious and multifaceted endeavor that requires strategic planning, resource management, and diplomatic finesse. As players progress through the game’s Space Stage, they must expand their empire by colonizing planets, forging alliances, or dominating through military might. Success hinges on mastering the game’s economy, leveraging tools like the Spice trade, and upgrading spacecraft with advanced weapons and tools. Balancing exploration, diplomacy, and conquest is key, as players navigate interactions with diverse alien civilizations, some of which may become allies, trade partners, or formidable foes. With patience, creativity, and a keen understanding of the game’s mechanics, players can rise from a single planet to a galactic superpower, shaping the destiny of the universe in *Spore*.
| Characteristics | Values |
|---|---|
| Game Stage | Space Stage |
| Primary Goal | Achieve a 100% Galactic Empire by controlling all inhabited planets |
| Key Mechanics | Alliance/Diplomacy, Conquest, Spice Trade, City Building |
| Alliance Strategy | Ally with weaker empires, exploit their resources, then conquer them |
| Conquest Methods | - Diplomatic Conversion (allies) - Economic Takeover (spice control) - Military Invasion (destroy cities, abduct leaders) |
| Spice Importance | Essential for empire growth, trade, and weapon production |
| City Building | Construct entertainment buildings to increase city size and spice production |
| Military Strategy | - Focus on powerful ships (Epic and Colossus) - Use grox-like creatures for ground assaults |
| Grox Threat | Powerful AI empire that must be defeated or avoided |
| Time Investment | Requires significant gameplay time (10+ hours) |
| Difficulty | Challenging, requires strategic planning and resource management |
| Achievement | Unlocks the "Galactic Core" and special rewards |
Explore related products
What You'll Learn
- Master Cell Stage Evolution: Optimize survival, dominate ecosystem, unlock genetic upgrades for advanced galactic conquest
- Strategic Tribal Dominance: Unite tribes, eliminate rivals, secure resources for civilization growth
- City-Building Efficiency: Balance military, economy, and culture to expand empire rapidly
- Space Exploration Tactics: Colonize planets, ally or conquer, harness Spice for power
- Diplomacy vs. Warfare: Choose alliances wisely, use espionage, or crush opponents for galactic supremacy

Master Cell Stage Evolution: Optimize survival, dominate ecosystem, unlock genetic upgrades for advanced galactic conquest
The Cell Stage in *Spore* is the foundation of your galactic empire, yet many players rush through it, missing critical opportunities to optimize their species’ future. Survival here isn’t just about eating and avoiding predators; it’s about strategic evolution that sets the stage for dominance. Start by prioritizing defense and speed upgrades early. These traits not only protect you from predators but also allow you to outmaneuver competitors for food. For instance, investing in the Electric Shock ability can deter larger organisms, while Speed Boost ensures you’re first to reach nutrient-rich areas. Think of this stage as a microcosm of galactic conquest: every decision shapes your species’ adaptability and strength.
Once survival is secured, focus on dominating the ecosystem. This isn’t just about being the apex predator; it’s about controlling resources and eliminating competition. Use your upgraded abilities to hunt rival cells systematically, reducing their population and securing more food for yourself. For example, combining Grab with Poison can neutralize threats efficiently. Additionally, explore the environment thoroughly to find hidden DNA strands, which unlock genetic upgrades. These upgrades are your species’ first taste of customization—a precursor to the advanced tools you’ll wield in space. Prioritize upgrades that enhance energy capacity and attack power, as these will compound your advantages in later stages.
The true power of the Cell Stage lies in its genetic upgrades, which lay the groundwork for advanced galactic conquest. Each upgrade you unlock here translates into traits and abilities for your creature in subsequent stages. For instance, choosing Pack Hunter early can evolve into social behaviors that benefit your tribe later. Similarly, investing in Omnivore traits ensures your species can adapt to diverse environments, a critical skill for colonizing alien worlds. Think long-term: the decisions you make here aren’t just about surviving the ocean—they’re about building a species capable of thriving across the galaxy.
To maximize your Cell Stage evolution, adopt a balanced approach. While aggression and defense are key, don’t neglect social interactions. Forming symbiotic relationships with other cells can provide protection or access to resources, mirroring the alliances you’ll form in space. For example, aligning with a Filter Feeder can grant you safe passage through dangerous areas. Finally, remember that time is your ally. Rushing through this stage limits your potential; instead, spend 10–15 in-game minutes optimizing your cell’s genetics. This investment pays dividends when you’re conquering star systems, as your species’ inherent strengths become the backbone of your empire. Master the Cell Stage, and the galaxy becomes yours to command.
Effective Mold Removal: Safely Clean Your Refrigerator Without Spreading Spores
You may want to see also

Strategic Tribal Dominance: Unite tribes, eliminate rivals, secure resources for civilization growth
In the tribal stage of Spore, the foundation for galactic conquest is laid through strategic dominance. The key lies in understanding the delicate balance between unity and aggression. Begin by identifying neighboring tribes with complementary strengths—perhaps one excels in food gathering while another is adept at combat. Use the social tool to ally with these tribes, sharing resources and defending each other from common threats. This symbiotic relationship not only strengthens your collective power but also reduces the number of potential rivals. However, alliances should be temporary; once your tribe is sufficiently fortified, absorb these allies into your fold, ensuring their loyalty through shared prosperity or, if necessary, coercion.
Elimination of rivals is a critical step, but it requires precision. Avoid direct confrontation with stronger tribes unless you have a clear advantage. Instead, employ guerrilla tactics: raid their food sources, disrupt their alliances, and isolate them from potential allies. Use the terrain to your advantage—ambush them in narrow passages or lure them into traps. Remember, the goal is not just to defeat them but to dismantle their ability to resist. Once weakened, strike decisively, ensuring their resources and territory are seamlessly integrated into your growing empire.
Securing resources is the lifeblood of civilization growth. Focus on controlling key areas rich in food, spices, and gems. Establish multiple settlements to maximize resource extraction, but avoid overextending your defenses. Prioritize upgrading your tribe’s tools and abilities, such as better weapons or faster movement, to maintain dominance. Trade routes can also be established with non-threatening tribes to ensure a steady supply of rare resources. However, always be prepared to cut off these routes if they become a liability.
A cautionary note: unchecked aggression can lead to isolation. While eliminating rivals is essential, indiscriminate attacks may unite other tribes against you. Maintain a facade of diplomacy when necessary, using gifts and alliances to buy time or distract potential enemies. Additionally, over-reliance on a single resource can leave your tribe vulnerable to scarcity. Diversify your economy by controlling multiple resource types and adapting to environmental changes.
In conclusion, strategic tribal dominance in Spore is a game of calculated alliances, targeted aggression, and resource management. By uniting tribes under your banner, eliminating threats methodically, and securing diverse resources, you lay the groundwork for a civilization capable of conquering the galaxy. This stage is not just about survival—it’s about building an unassailable foundation for the epic journey ahead.
Can Stun Spore Effectively Counter Excadrill in Competitive Battles?
You may want to see also

City-Building Efficiency: Balance military, economy, and culture to expand empire rapidly
In the vast expanse of the galaxy within *Spore*, the key to rapid empire expansion lies in the delicate balance of military might, economic prosperity, and cultural influence. Each city you establish is a microcosm of this triad, and its efficiency determines the pace of your galactic conquest. Neglect one aspect, and your empire risks stagnation or vulnerability. Master the balance, and your cities become unstoppable engines of growth.
Consider the economic foundation first. A thriving economy fuels both military campaigns and cultural initiatives. Focus on maximizing resource production by strategically placing cities near high-yield deposits of spices, gems, or rare minerals. Invest in trade routes early to establish a steady income stream, but avoid over-reliance on a single resource. Diversify your economy by fostering multiple industries, such as entertainment and healthcare, to ensure resilience against market fluctuations. For instance, a city with a Level 3 Spice Grove and a Level 2 Gem Mine, supplemented by a Trade Depot, can generate enough income to fund both a small fleet and cultural upgrades.
Military efficiency is not about brute force but strategic deployment. Prioritize building a fleet capable of defending your cities and projecting power, but avoid overextending your resources. Focus on upgrading key ships with advanced weapons and shields rather than mass-producing weaker units. Establish military outposts in contested regions to secure trade routes and deter rivals. A well-timed strike with a Level 5 War Barge can cripple an enemy’s economy, but only if your own cities are secure. Remember, a strong defense allows for aggressive expansion without risking collapse.
Culture is the silent conqueror, capable of turning rivals into allies without firing a shot. Invest in cultural buildings like Epicenter Towers and Groove-a-Tron Dance Floors to increase your empire’s appeal. Use diplomatic tools like gifts and alliances to neutralize threats before they escalate. For example, sending a Level 3 Spice Gift to a neighboring empire can delay conflict, giving you time to fortify your borders. Cultural dominance also unlocks powerful tools like the Monolith, which can convert entire planets to your cause. However, balance cultural spending with economic and military needs; over-investment can leave your cities defenseless.
The ultimate takeaway is that city-building efficiency in *Spore* is a dynamic process, requiring constant adjustment to shifting galactic conditions. Monitor your empire’s health by tracking resource production, fleet strength, and cultural influence. Use the City Advisor tool to identify bottlenecks and allocate resources accordingly. For instance, if a city’s happiness drops below 50%, prioritize entertainment buildings to prevent rebellion. By maintaining equilibrium among military, economy, and culture, your cities will not only survive but thrive, propelling your empire to galactic dominance.
Do Viruses Form Spores? Unraveling the Survival Strategies of Microbes
You may want to see also
Explore related products

Space Exploration Tactics: Colonize planets, ally or conquer, harness Spice for power
In the vast expanse of the Spore galaxy, the key to dominance lies in a strategic blend of expansion, diplomacy, and resource management. Colonizing planets is the cornerstone of your empire’s growth. Each planet offers unique resources and environments, from arid deserts to lush jungles, each with its own challenges and rewards. Prioritize planets rich in Spice, a rare and powerful resource that fuels your empire’s technological advancements and military might. Establish colonies swiftly but thoughtfully, ensuring they are well-defended against rival civilizations. Remember, a single vulnerable outpost can become a foothold for enemies seeking to dismantle your empire.
Allying or conquering other civilizations is a delicate dance of power and strategy. Alliances can provide temporary stability, granting access to shared resources and protection against common foes. However, alliances are fragile and often short-lived. Assess the strength and ambitions of potential allies carefully; a weak ally may become a liability, while a strong one might turn on you when your guard is down. Conquest, on the other hand, offers immediate control over resources and territory but requires significant military investment. Use espionage to weaken your target before striking, and always leave enough forces to secure newly conquered planets against rebellion.
Spice is the lifeblood of your galactic empire, a resource so vital that its control can determine the fate of civilizations. Harvest Spice from colonized planets and use it to upgrade your ships, weapons, and defenses. Establish trade routes to ensure a steady supply, but guard them fiercely, as they are prime targets for raiders. Research Spice-enhancing technologies early in your expansion to maximize its benefits. A single Spice-rich planet can tip the balance of power in your favor, but over-reliance on a single source leaves you vulnerable to blockades or sabotage.
Balancing colonization, diplomacy, and Spice management requires constant vigilance and adaptability. Monitor the actions of rival empires, anticipating their moves before they threaten your dominance. Use scouts to map uncharted territories and identify potential targets for colonization or conquest. Invest in a diverse fleet, combining fast strike ships for conquest with sturdy defenders to protect your colonies. Above all, remain ruthless in your pursuit of power, for in the Spore galaxy, hesitation is the first step toward extinction.
Can You Play Mouthwashing on Mac? A Comprehensive Guide
You may want to see also

Diplomacy vs. Warfare: Choose alliances wisely, use espionage, or crush opponents for galactic supremacy
In the vast expanse of *Spore’s* galaxy, the path to supremacy hinges on a critical choice: diplomacy or warfare. Each approach carries unique advantages and risks, demanding strategic foresight. Diplomacy allows you to forge alliances, share resources, and expand influence without direct conflict, but it requires patience and careful negotiation. Warfare, on the other hand, offers immediate control over territories and resources but can provoke widespread hostility and drain your empire’s stability. The key lies in understanding when to extend an olive branch and when to wield a sword.
Consider the art of alliance-building as a cornerstone of diplomatic conquest. Aligning with weaker empires can grant you access to their resources and territories without expending military might. However, choose your allies wisely—a backstabbing ally can cripple your progress. Use espionage to monitor their intentions; sending spies to gather intelligence ensures you’re never caught off guard. For instance, if an ally begins amassing troops near your border, it’s a clear signal to either strengthen defenses or preemptively sever ties. Remember, diplomacy is not about trust but about mutual benefit.
Warfare, while brutal, can be a swift path to dominance if executed strategically. Focus on neutralizing threats before they escalate by targeting empires with valuable assets or strategic locations. Use your military to blockade trade routes, crippling opponents economically before launching a full-scale invasion. However, unchecked aggression can unite the galaxy against you. To mitigate this, employ a divide-and-conquer strategy: isolate your enemies by forming temporary alliances with their rivals, then strike when they’re weakened. For example, declaring war on a distant empire while maintaining peace with neighboring powers minimizes the risk of a two-front conflict.
The most effective conquerors in *Spore* blend diplomacy and warfare seamlessly. Use diplomacy to buy time, gather resources, and isolate targets, then deploy military force to secure key victories. Espionage acts as the bridge between these approaches, providing the intelligence needed to make informed decisions. For instance, infiltrating an enemy empire to sabotage their economy can weaken them enough for a diplomatic takeover, avoiding the costs of war. This hybrid strategy maximizes efficiency while minimizing backlash, ensuring your empire remains a dominant force in the galaxy.
Ultimately, the choice between diplomacy and warfare depends on your empire’s strengths, the galactic landscape, and your long-term goals. A resource-rich empire might prioritize diplomacy to expand trade networks, while a militaristic empire could focus on rapid conquest. Regardless of your approach, adaptability is crucial. Monitor the actions of other empires, reassess your strategies regularly, and be prepared to pivot when opportunities arise. Galactic supremacy in *Spore* is not won through brute force or charm alone but through the calculated interplay of both.
How Long Do Dried Mold Spores Survive on Surfaces?
You may want to see also
Frequently asked questions
Focus on expanding your empire through colonization, diplomacy, or conquest. Build a strong economy by controlling spice geysers, trade routes, and city production. Upgrade your ships and weapons to outmatch opponents, and use alliances strategically to weaken enemies before attacking.
Use diplomacy to weaken alliances between empires, bribe weaker factions to join your side, and declare wars only when you have a clear advantage. Offering gifts and signing treaties can delay conflicts, giving you time to build up your forces.
Upgrading your tools, such as the terraforming tool and the planet buster, allows you to reshape planets to your advantage and eliminate threats quickly. Prioritize weapon and shield upgrades for your ships to dominate space battles and secure your dominance.